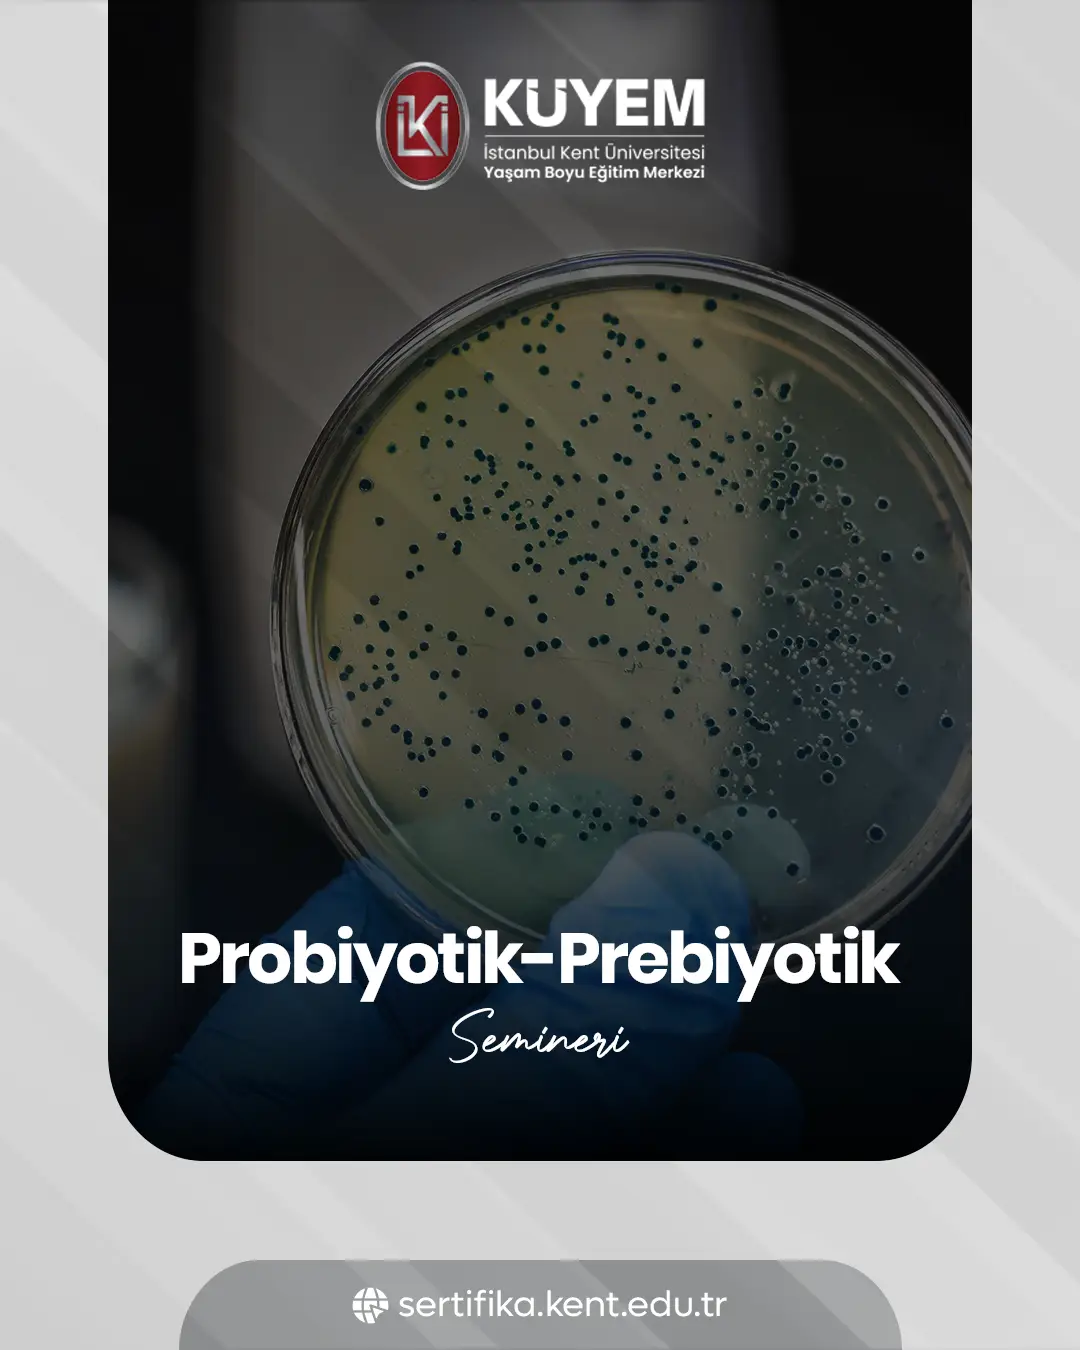
Probiyotik-Prebiyotik Semineri

Yorumlar
Probiyotik-Prebiyotik Semineri
₺799,00
Bağırsak sağlığınızı iyileştirin! Probiyotik-Prebiyotik Semineri ile sağlıklı bir yaşamın kapılarını aralayın. Bilgi dolu bu eğitime hemen katılın.
Öne Çıkanlar
Eğitime Anında Başla
Kamu ve Özel Sektörde Geçerli
Bilgisayar, Telefon ve Tabletten Erişim
Probiyotik-Prebiyotik Semineri
Bağırsak sağlığınızın genel iyiliğiniz üzerindeki etkisini anlamak ister misiniz? Günümüzdeki yaşam tarzı ve beslenme alışkanlıklarımız, hassas bağırsak dengemizi kolayca bozabilir. Bu durum, pek çok sağlık sorununa zemin hazırlayabilir. Probiyotik ve prebiyotiklerin bu dengeyi nasıl yeniden kurduğuna dair derinlemesine bir anlayış geliştirebilirsiniz.
Bu çevrimiçi seminer, probiyotik ve prebiyotiklerin temel prensiplerini pratik bilgilerle harmanlayarak sunar. Öğreneceklerinizi günlük yaşamınıza ve beslenmenize kolayca entegre etmenin yollarını keşfedecek, gıda seçimlerinizi bilinçli bir şekilde yapma becerisi kazanacaksınız. Kendi bağırsak sağlığınız üzerinde aktif rol almanın gücünü hissedeceksiniz.
Sağlıklı bir yaşam için önemli bir adım atın. Probiyotik-Prebiyotik Semineri ile sindirim sisteminizi destekleyin ve genel yaşam kalitenizi artırın. Kendi sağlığınızın kontrolünü elinize alın.
Başlayın.
Eğitim programını tamamlayarak alacağınız sertifikayı özgeçmişinize ekleyebilir ve kariyer fırsatlarınızı artırabilirsiniz. İstanbul Kent Üniversitesi onaylı bu sertifika, e-Devlet üzerinden sorgulanabilir özelliktedir.
Aldığınız sertifika, kişisel ve mesleki gelişiminize önemli bir katkı sağlayacaktır. Eğitim süreci boyunca kazandığınız bilgiler ve yetkinlikler, kariyerinizde daha başarılı bir noktaya ulaşmanıza destek olacaktır.
Bu eğitim programına şu kişiler başvurabilir:
- İlgili alanda çalışan profesyoneller,
- İlgili alandan mezun bireyler,
İlgili alanda eğitimine devam eden öğrenciler.
"Eğitime Katıl" butonuna tıklayarak kayıt işleminizi tamamlayabilirsiniz. Sistem, sizi tüm adımlar konusunda yönlendirecektir. Ödemenizi şu yöntemlerden biriyle gerçekleştirebilirsiniz:
- Banka/Kredi Kartı,
- Havale/EFT.
Ödeme ve İşlem Detayları:
- Kredi Kartı ile Ödeme: İşleminiz 60-120 saniye içinde tamamlanır. Öğrenci numaranız oluşturulur ve giriş bilgileriniz SMS ile size iletilir.
- Havale/EFT ile Ödeme: Mesai saatleri içinde yapılan ödemelerde aynı gün, mesai saatleri dışında yapılan ödemelerde ise ilk iş günü bilgilerinize erişim sağlanır ve SMS bilgilendirmesi yapılır.
Kayıt ve ilerleme sürecinizi "Öğrenci Paneli" üzerinden görüntüleyebilir, ayrıca SMS ile gönderilen bilgilendirmelerden faydalanabilirsiniz.
Önemli Not: Bu program yalnızca sertifikalandırma hizmeti sunmaktadır ve mesleki gelişim amacıyla hazırlanmıştır.
- Tüm eğitim süreci tamamen online gerçekleşmektedir.
- Eğitim videolarına ve içeriklere 7/24 erişim sağlayabilirsiniz.
- Eğitimi tamamlamak için toplam 60 günlük bir süre tanınmaktadır. Bu süre sonunda eğitim ve sınav erişiminiz kapanacaktır.
Süre Uzatma: 60 gün içinde tamamlanamayan eğitimler için ek ödeme karşılığında süre uzatma talep edebilirsiniz.
Kent LMS platformu; bilgisayar, tablet ve akıllı telefonlar ile uyumludur. Size en uygun cihazla erişim sağlayabilirsiniz.
Başvuru sırasında verdiğiniz bilgilerle oluşturulan kullanıcı adı ve şifre, size SMS yoluyla iletilir. Bu bilgilerle sisteme kolayca giriş yapabilirsiniz.
Bilgilerinizi doğru girdiğinizden emin olun. Özellikle T.C. kimlik numarası ve ad-soyad gibi alanlarda noktalama işaretlerine dahi dikkat edilmelidir. Sorun devam ederse, KÜYEM danışma hattıyla iletişime geçmeniz önerilir.
Eğer kişisel bilgilerinizde (isim, T.C. kimlik no, telefon gibi) hata varsa, güncelleme için mutlaka KÜYEM eğitim danışmanlarıyla iletişime geçmeniz gereklidir. Aksi halde belgelerde sorun yaşanabilir.
Öğrenci Panelinizde yer alan "Programlarım" sekmesinden ilgili derslerinize ulaşabilirsiniz.
Öğrenci Panelinizde yer alan "Eğitimlerim" sekmesinden ilgili derslerinize ulaşabilirsiniz.
"Eğitimlerim" sekmesinden katıldığınız tüm dersleri görebilirsiniz. Herhangi bir dersi seçerek içeriğe ulaşabilirsiniz.
Bu tamamen sizin tercihinize bağlıdır. Dilediğiniz eğitimden başlayabilirsiniz.
Öncelikle modeminizi yeniden başlatmayı deneyin. Eğer sorun devam ederse, farklı bir cihazla giriş yapmayı deneyin. Yine de video açılmıyorsa KÜYEM teknik destek birimi size yardımcı olacaktır.
Videoların izlenme süresi sistem tarafından takip edilir. Tüm videoyu izledikten sonra süre göstergesi yeşile döner. Bu gerçekleşmiyorsa destek birimiyle iletişime geçin.
Evet, kayıt olduğunuz program kapsamındaki tüm dersleri izlemeniz zorunludur. Eksik izlenen içerikler sınav sistemine geçişinizi engelleyebilir.
Tüm videoları eksiksiz izleyip sistemde "tamamlandı" olarak işaretlenmesini sağladıktan sonra, sınav modülü aktif hale gelir.
Hayır. Öğrencilik süreniz boyunca, istediğiniz zaman sınava giriş yapabilirsiniz.
Sistem menüsündeki "Sınavlarım" bölümünden aktif sınavınıza ulaşabilirsiniz. (Not: Seminer programlarında sınav bulunmaz.)
Belirlenen süre içerisinde soruları yanıtlayıp "Sınavı Tamamla" butonuna sadece bir kez tıklamanız yeterlidir. Tekrar tekrar tıklamanız sınav hakkınızı etkileyebilir.
Soru sayısı eğitim içeriğine göre değişiklik gösterir ve genellikle 10 ila 50 soru arasında olur.
Her eğitim programının seviyesi farklıdır (Başlangıç, Orta, İleri). Eğitim detaylarını inceleyerek hangi seviyeye uygun olduğunu öğrenebilirsiniz.
Toplamda 3 ücretsiz sınav hakkınız vardır. Eğer bu hakların tümünü kullanır ve hala başarılı olamazsanız, ek sınav hakkı ücretle tanımlanabilir. (Aile Danışmanlığı Eğitimi'nde sınav hakkı 1 adettir.)
Sınavı tamamladıktan sonra "Sonuçları Gör" seçeneğine tıklayarak başarılı ya da başarısız olduğunuzu öğrenebilirsiniz.
Sıklıkla Birlikte Alınanlar
Kullanıcı Yorumları ve Derecelendirmeleri
3 yoruma göre
Düşüncelerinizi Paylaşın
Bu eğitim hakkındaki deneyimlerinizi ve geri bildirimlerinizi diğer kullanıcılarla paylaşarak onlara yardımcı olun.
Yeni Bir Yorum Ekle
Son Yorumlar
Neh*********
Yeni bakış açılarıyla düşünmek için güzel bir akış sağladı. Bu konuları daha derinlemesine keşfetmek heyecan verici.
Zeh*******
Farklı bir pencere açıldı, bu da konuyu anlamak için güzel bir başlangıç oldu. Böylece daha önce düşünmediğim bağlantıları kurmaya başladım.
Öme*******
Birkaç yeni düşünce adımı atmamı sağladı. Bu konular arasındaki ilişkiyi daha net görmek motive ediciydi.









